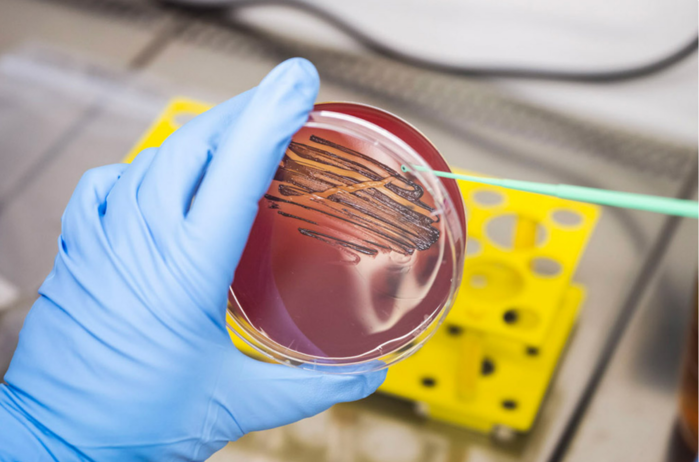

3분 읽기
- 치주염은 잇몸 질환으로, 거의 모든 사람의 절반이 일생 한 번쯤은 잇몸 염증 경험
- 만성 치주염은 전신 건강에도 악영향; 암, 심혈관 질환, 알츠하이머병의 발병 위험 높여
- 클로르헥시딘 함유 치약, 구강청정제;병원균과 세균의 경쟁자인 길항균까지 사멸시켜
- 새 개발물질은 단순히 치은염 병원균을 죽이는 것이 아니라, 성장을 억제하는 것
- 개, 고양이 치주염 원인이 매우 유사, 반려동물용 제품 개발 또한 고려 대상
새로운 치약, 치주염 유발균을 억제하다
활성 성분이 잇몸 염증의 주요 원인균의 성장을 선택적으로 억제한다
잇몸 염증 완화:
새롭게 발견된 물질이 기존 치약 및 구강청정제보다 더욱 효과적이고 지속적으로 치주염을 치료한다. 이 활성 성분은 잇몸 염증을 유발하는 주요 병원균 중 단 하나의 성장만을 선택적으로 억제하기 때문이다. 그 결과, 건강한 구강 내 유익균은 유지되고 병원균의 재증식을 늦출 수 있다. 이 활성 성분을 함유한 치약이 출시되었다.
 |
| ▲ 치주염의 주요 원인균인 포르피로모나스 진지발리스(Porphyromonas gingivalis, 주황색)를 대상으로 새로운 활성 성분(파란색)이 개발됐다. 이 성분은 구강 내 다른 세균총에는 영향을 주지 않고 포르피로모나스 진지발리스의 성장만을 선택적으로 억제한다. © PerioTrap |
치주염은 잇몸 질환으로, 거의 모든 사람의 절반이 일생 한 번쯤은 잇몸 염증을 경험한다. 치주염이 지속되면 심한 경우 턱뼈 손실과 치아 상실로 이어질 수 있다. 또한 만성 치주염은 구강 건강뿐 아니라 전신 건강에도 악영향을 미칠 수 있다. 암, 심혈관 질환, 심지어 알츠하이머병의 발병 위험을 높이는 것으로 알려져 있다. 치주염은 구강 내 특정 세균, 특히 포르피로모나스 진지발리스(Porphyromonas gingivalis)에 의해 발생한다.
하지만 문제는 알코올이나 소독제인 클로르헥시딘이 함유된 치약이나 구강청정제와 같은 일반적인 치주염 치료제가 치주염 병원균뿐만 아니라 이러한 세균의 경쟁자와 길항균까지 사멸시킨다는 점이다. 치료 후 구강 내 세균총이 재생되면 치주염 병원균은 염증이 생긴 잇몸에서 특히 잘 증식하기 때문에 유리한 위치를 차지하게 된다. 반면 건강한 세균은 더디게 증식한다. 결과적으로 치주염은 계속 재발한다.
치주염 병원균 선택적 억제하지만 미래에는 이러한 상황이 바뀔 수 있다. 할레에 있는 프라운호퍼 세포 치료 및 면역학 연구소(IZI)의 스테판 실링(Stephan Schilling)이 이끄는 연구팀은 다른 세균에는 해를 끼치지 않으면서 포르피로모나스 진지발리스와 같은 치주염 병원균을 선택적으로 차단하는 물질을 발견했다. "이 물질은 단순히 치은염 병원균을 죽이는 것이 아니라, 성장을 억제하는 것이다"고 쉴링은 설명했다. 이를 통해 구강 내 미생물총이 정상화되고 치주염 병원균의 증식을 억제할 수 있다.
|
| ▲ 치주염의 주요 원인균 중 하나인 포르피로모나스 진지발리스 배양액.
© Nilz Böhme |
초기 연구에 따르면, 이 억제 물질은 치아 표면의 바이오필름 형성을 약 25% 감소시키고, 바이오필름 내 세균 활동 또한 저하시킨다. 또한, 연구진에 따르면 이 물질은 포르피로모나스 진지발리스(Porphyromonas gingivalis)의 잇몸 조직 침투를 억제하고 염증 지표를 감소시키는 효과도 있다.
활성 성분에서 치약까지이 물질을 기반으로 효과적이고 상용화 가능한 치약을 개발하는 데에는 상당한 노력이 필요했다. 제품은 원치 않는 세균을 차단해야 하지만 독성이 없어야 한다. 또한, 체내에 흡수되어 혈류로 들어가거나 치아 변색을 유발해서도 안 된다. 이러한 연구를 수행하고 치약을 완성하기 위해 프라운호퍼 연구원 몇 명이 2018년에 페리오트랩 제약(PerioTrap Pharmaceuticals)이라는 회사를 설립했다.
프라운호퍼 IZI 및 프라운호퍼 재료 및 시스템 미세구조 연구소 IMWS와의 긴밀한 협력을 통해 페리오트랩 치약이 개발되었다. 프라운호퍼 스핀오프 기업의 설립자 중 한 명인 미르코 부흐홀츠(Mirko Buchholz)는 "이 제품은 치주염 예방을 위해 설계되었다. 일반 치약처럼 연마제와 충치 예방을 위한 불소도 함유되어 있다"고 설명했다. 쉴링은 "단순히 새로운 성분을 넣은 좋은 치약을 개발한 것이 아니라, 고품질의 의료 등급 구강 관리 제품을 개발했다"고 덧붙였다.
 |
▲ 연구진은 이 새로운 활성 성분을 함유한 치약과 전문가용 치아 세정 젤을 출시했다. © PerioTrap |
케어 젤과 구강청정제 개발 예정연구원들의 연구는 계속 진행 중이다. 이미 치과에서 사용하는 케어 젤을 개발했는데, 이는 전문적인 치아 세척 후 사용하는 제품으로, 병원성 세균을 억제하고 구강 내 미생물 균형을 유지하며 잇몸 건강을 지켜준다. 더 나아가, 과학자들은 현재 치주염 억제 물질을 함유한 구강 세정제 개발에 힘쓰고 있다.
미래에는 반려동물도 이러한 특별한 치과 치료의 혜택을 받을 수 있을 것이다. 개와 고양이의 치주염은 원인이 매우 유사하기 때문에 반려동물용 제품 개발 또한 고려 대상이다.
출처: 프라운호퍼 연구소
[더사이언스플러스=문광주 기자]
[저작권자ⓒ the SCIENCE plus. 무단전재-재배포 금지]